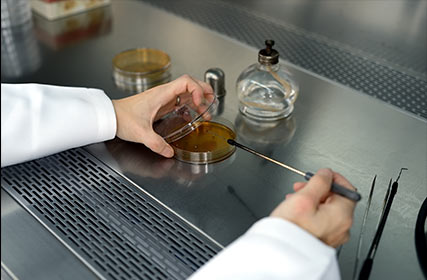
無菌操作台

實驗室設備

高效能離心分配層析儀

培養振盪器

離心器

液相層析串連是質譜儀
無菌操作台

分光光度計

旋轉真空減壓濃縮機

光學顯微鏡












